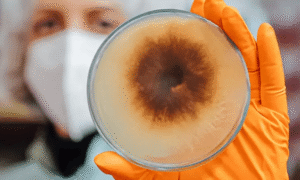

Od zgodovinske uporabe do sodobnih raziskav
Zdravilne gobe in glive imajo bogato, tisočletja staro zgodovino uporabe. Starodavne kulture po vsem svetu so jih cenile zaradi njihovih zdravilnih lastnosti, ki so jim pomagale ohranjati vitalnost, zdraviti rane ter krepiti odpornost. Danes številne raziskave potrjujejo, da vsebujejo široko paleto bioaktivnih spojin, ki pozitivno vplivajo na naše zdravje.
Zdravilne glive in gobe znane po svojih adaptogenih in imunomodulatornih lastnostih, pomagajo telesu obvladovati stres in izboljšujejo delovanje imunskega sistema. Prvi antibiotik je bil izoliran iz gliv, kar dokazuje njihov potencial pri zdravljenju različnih bolezni.

MycoMedica: zavezanost k kakovosti in trajnosti
V sodobnem svetu postaja uživanje gob in gliv nepogrešljivi del k zdravju in dobremu počutju zavezanega življenjskega sloga.
Podjetje MycoMedica iz Podkorena pri Kranjski Gori izstopa kot simbol odličnosti na področju prehranskih dopolnil iz zdravilnih gob in gliv, združenih pod blagovno znamko GOBA®.
V podjetju MycoMedica razpolagajo z največjo slovensko zbirko kultur gojenih in zdravilnih gliv, ki predstavlja jedro njihove proizvodnje in raziskav. So svetovno priznani gojitelji in predelovalci ter zagotavljajo, da so vse uporabljene surovine 100% evropskega izvora in najvišje ekološke kakovosti. V proizvodnem procesu uporabljajo inovativne okolju prijazne pristope.
Prehranska dopolnila GOBA® so testirana v vrhunskih laboratorijih doma in v tujini in ustrezajo najstrožjim standardom kakovosti.
Zaupanje, ki temelji na raziskavah
Učinkovitost izdelkov GOBA® temelji na znanstvenem pristopu raziskovalne skupine pod vodstvom doc.dr. Andreja Gregorija, cenjenega raziskovalca, ki je svoje življenje posvetil gojenju, predelavi in raziskovanju zdravilnih učinkov teh naravnih čudežev. Njihove raziskave so objavljene v številnih strokovnih in znanstvenih publikacijah.
Ena od bistvenih prednosti je, da študije izvedene na prehranskih dopolnilih GOBA® v sodelovanju s svetovno priznanimi znanstvenimi inštitucijami, dokazujejo terapevtske učinke zdravilnih gliv, zlasti v zvezi z nevrodegenerativnimi, presnovnimi in avtoimunimi boleznimi, protirakavim delovanjem in s splošno podporo imunskemu sistemu.

Prepoznavne zdravilne gobe in njihovo delovanje
Med najbolje raziskane gobe sodi svetlikava pološčenka – Ganoderma lucidum – imenovana tudi goba nesmrtnosti. Njene aktivne spojine, kot so triterpeni in polisaharidi, aktivirajo imunski sistem in uravnavajo raven holesterola ter sladkorja v krvi. V Aziji jo že desetletja uporabljajo pri zdravljenju različnih oblik rakavih obolenj, na podlagi dokazov kliničnih študij so jo na Japonskem uvrstili celo na uradno listo zdravil. Pacienti, ki so zaužili izdelke iz te gobe, so imeli manj infekcij, povišala se je produkcija protiteles, izboljšala imunska odpornost, ublažili so se neželeni učinki kemoterapij in obsevanj, kot so utrujenost, slabost, nespečnost, bolečine, izpadanje las in podobno. Učinkovita je tudi pri razstrupljanju telesa, na kar nakazuje nedavna raziskava izvedena na prehranskem dopolnilu GOBA® Galimmun®, ki je pokazala, da izdelek nase zelo učinkovito veže težke kovine.
Snovi v glivah, kot je na primer kordicepin iz glive Cordyceps, preprečujejo razmnoževanje virusov. Raziskave dokazujejo, da codryceps deluje protivnetno in pozitivno vpliva proti protinu, artritisu in bolečim, otečenim sklepom. Poleg tega izboljša privzem kisika v kri, s čimer pozitivno vpliva na zmogljivost, vzdržljivost ter pospešuje regeneracijo mišic. Posebej priljubljen je med ljudmi, ki imajo težave z dihali, med ljubitelji aktivnega življenja in vrhunskimi športniki. Prehranska dopolnila GOBA® CordyVit® podjetja MycoMedica vsebujejo eno najvišjih koncentracij kordicepina na svetu.
Glive in gobe ščitijo črevesni mikrobiom ter preprečujejo razrast neželenih mikroorganizmov. Na izdelku GOBA®Hericium erinaceus so v klinični študiji dokazali izboljšanje kognitivnih sposobnosti ter povečanje pestrosti črevesnega mikrobioma. Ob uživanju dopolnila iz glive Hericium se v telesu sproščajo snovi, ki ugodno vplivajo na živčevje in na imunski sistem prebavnega trakta. Raziskava izvedena na 55 pacientih z avtoimunimi boleznimi prebavil, je pokazala, da je prehransko dopolnilo iz glive hericium izredno učinkovit proti Crohnovi bolezni, ulceroznemu kolitisu in bolezni razdraženega črevesja.

Raznolika paleta izdelkov
MycoMedica je predana zagotavljanju vrhunskih izdelkov, ki jim stranke lahko zaupajo.
Poleg zgoraj omenjenih proizvodov so v podjetju MycoMedica razvili tudi posebej prilagojene mešanice zdravilnih gliv in gob. Mešanica MycoMix®Activ je dopolnilo, namenjeno ljudem z aktivnim življenjskim slogom in vrhunskim športnikom. MycoMix®50+ so razvili posebej za starejše, ki se srečujejo s hormonskimi nihanji, bolečimi sklepi, pešanjem kognitivnih sposobnosti in nevrodegenerativnimi obolenji. MycoMix®Immun pomaga pri ohranjanju odpornosti in vitalnosti ter okrevanju po bakterijskih in virusnih okužbah. MycoMix®Onca pa se uporablja kot podporno dopolnilo ob kemoterapijah in obsevanjih.